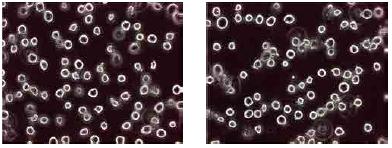
产品细节图片7

相关产品推荐更多 >
万千商家帮你免费找货
0 人在求购买到急需产品
- 详细信息
- 文献和实验
- 技术资料
- 库存:
999
- 供应商:
北京诺博莱德科技有限公司
产品品牌:Wako
产品名称:BES 特异性荧光探针
产品货号:021-17801
产品规格:1 mg
超氧化物特异性荧光探针 BES-So-AM / BES-So
◆特点
● 比氢化乙啡啶(hydroethidine)有更高的特异性
● 与超氧化物特异性反应,用于监测活细胞内超氧化物水平
● BES-So-AM 可穿透细胞膜,无需打孔
● 几乎不溶于水,可制成水溶液使用
● 可用于荧光显微镜、流式细胞仪

■ 细胞通透性
| 产品编号 | 产品名称 | Ex/Em(nm) |
| 021-17801 | BES-So-AM | 505/544 |
■ 无细胞通透性
| 产品编号 | 产品名称 | Ex/Em(nm) |
| 025-18921 | BES-So | 505/544 |
◆使用举例

图1)是 Jurkat T 细胞在含 33 μM BESSo-AM 的培养基中 37° C 培养1小时,使探针进入细胞,然后添加5mM 丁酸(O2-• 诱导剂),
37° C 培养1小时;
图2)是 Jurkat T 细胞在含 33 μM BESSo-AM 的培养基中 37° C 培养1小时,使探针进入细胞, 然后不添加丁酸,
37° C 再培养1小时;
图3)是 Jurkat T 细胞在含 33 μM BESSo-AM 和 Tiron(O2-• 清除剂)的培养基中 37° C 培养1 小时,然后添加5mM的丁酸,
继续培养1个小时。
(数据提供:日本兵库医疗大学药学院前田初男)
过氧化氢特异性荧光探针 BES-H2O2-Ac / BES-H2O2
◆特点
● 比二氯荧光黄 (DCFH) 有更高的特异性
● 可动态监测活细胞内的过氧化氢
● BES-H2O2-Ac 可穿透细胞膜,无需打孔
● 几乎不溶于水,可制成水溶液使用
● 可用于荧光显微镜、流式细胞仪

■ 细胞通透性
| 产品编号 | 产品名称 | Ex/Em(nm) |
| 028-17811 | BES-H2O2-Ac | 485±20/515±20 |
■ 无细胞通透性
| 产品编号 | 产品名称 | Ex/Em(nm) |
| 025-18921 | BES-H2O2 | 485±20/515±20 |
◆使用举例
荧光图像
1)H2O2诱导刺激 2)无H2O2诱导刺激

相位差图像
图 1)和 2)是 Jurkat T 细胞用含 50 μM BES-H2O2-Ac 的培养基 37° C 培养1小时,使探针进入细胞。分别在添加5mM 丁酸(H2O2 诱导剂)和不添加丁酸的培养基中培养1小时。
(数据提供:日本兵库医疗大学药学院 前田初男)
R-SH/R-SeH 选择性荧光探针 BES-Thio
◆特点
● 与 R-SH 选择性反应(pH 7.4)
● 与 R-SeH 选择性反应(pH 5.8)
● 几乎不溶于水,酶反应与检测反应能同时进行
● 可用于胆碱酯酶活性测定等实验中-SH 的检测
| 产品编号 | 产品名称 | Ex/Em(nm) |
| 025-15481 | BES-Thio | 495/535 |
◆使用举例

左图为乙酰胆碱酯酶抑制剂(donepezil)对乙酰胆碱酯酶(AChE)及丁酰胆碱酯酶(BChE)的抑制曲线。
通过 Donepezil 的抑制作用, 用本品可确认 AChE 在 Donepezil 浓度较低范围内比 BChE 更易被选择性抑制。
检测原理:通过在含乙酰胆碱酯酶(AChE)的基质中使用乙酰胆碱、在含丁酰胆碱酯酶(BChE)的基质中使用丁酰胆碱,酶反应产生的硫代胆碱可用本品检测。
(数据提供:日本兵库医疗大学药学院 前田初男)
| 产品编号 | 产品名称 | 产品规格 | 产品等级 |
| 021-17801 | BES-So-AM | 1 mg | 细胞生物学用 |
| 028-16211 | BES-So(无细胞通透性) | 1 mg | 细胞生物学用 |
| 028-17811 | BES-H2O2-Ac | 1 mg | 细胞生物学用 |
| 024-18751 | BES-H2O2(无细胞通透性) | 1 mg | 细胞生物学用 |
| 025-15481 | BES-Thio | 1 mg | 细胞生物学用 |
风险提示:丁香通仅作为第三方平台,为商家信息发布提供平台空间。用户咨询产品时请注意保护个人信息及财产安全,合理判断,谨慎选购商品,商家和用户对交易行为负责。对于医疗器械类产品,请先查证核实企业经营资质和医疗器械产品注册证情况。
文献和实验sunk33 各位有没有听说过在丙酮丁醇梭菌中有一种能够响应丁醇的启动子,就是在丁醇存在的情况下能够启动该启动子下游基因的转录 谢谢 zhujoker 其实你题目就是说的错的,哪有什么丁醇特异性启动子?而是你想问的是丁醇能激活什么样的特异性启动子,像这种实验你可以考虑做双向,在用不用丁醇处理的情况下看蛋白的表达情况,然后筛选。 sunk33 谢谢版主指导 可能说法上不严
本文根据自身实验经验总结,针对 PCR 实验过程出现的问题举例,提供可实施的解决方法。并根据经验列举了提高 PCR 反应特异性的方法。 问题 1:假阴性(无扩增产物) 现象:正对照有条带,样品无条带 可能原因: · 模板:含有?Taq 酶抑制剂、杂蛋白,模板上样量低或模板降解 · 引物:引物降解,引物设计不合理 · 试剂:酶失活,buffer 不合适 · 反应条件:退火温度高,延伸时间短 解决方法: · 纯化模板并重新提取,并检测模板是否含有抑制剂 · 重新设计引物并低温保存 · 优化
陈秀英 彭孝军*(大连理工大学精细化工国家重点实验室 大连 116012)摘 要 介绍了各种DNA 荧光探针的结构特征、荧光性质和与DNA 的作用方式,概述了DNA 探针在生物分子分析方面的应用,并展望了DNA 荧光探针的发展趋势和应用前景。关键词 荧光探针 DNA 花菁染料 光稳定性 量子点DNA Fluorescence ProbesChen Xiuying, Peng Xiaojun*(State Key Laboratory of Fine Chemicals, Dalian
技术资料暂无技术资料 索取技术资料









